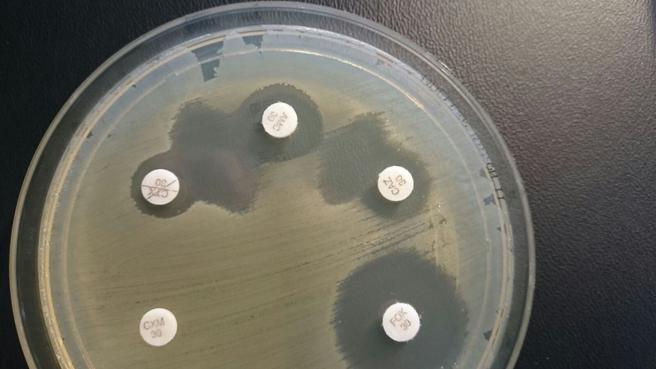
Las bacterias resistentes a los antibióticos, todo un problema para la medicina

Un nuevo paradigma científico podría estar a la vuelta de la esquina
De hecho, este procedimiento, aunque de una manera totalmente distinta, ya se lleva a cabo. Y es que el potencial de las bacterias sanas “se conoce desde hace un siglo”, subraya Casals-Pascual. “Lo que pasa es que la gente ha sido un poco escrupulosa al respecto”, puntualiza. Hoy en día, esta técnica se materializa a través de una colonoscopia, donde previamente se han obtenido las bacterias sanas de una persona con una microbiota saludable que se transfieren al paciente mediante lo que se conoce como un trasplante fecal.En el mundo animal, esta manera de proceder, llevada obviamente a la práctica mediante otra estrategia, está muy extendida. “Hay animales, como los pandas, los koalas, los hipopótamos o los elefantes, que se comen las defecaciones de sus madres. Y lo hacen para tener la flora bacteriana adecuada”, defiende este microbiólogo del Clínic. Hay estudios sólidos que demuestran, según este investigador, que las bacterias sanas acaban erradicando las malas.
El proyecto, que nace de la colaboración entre los departamentos de enfermedades infecciosas y de microbiología del Clínic, también podría tener aplicaciones en el campo de la salud mental debido a la curiosa conexión que existe entre el intestino (las tripas) y el cerebro.“El dolor de estómago repentino cuando nos ponemos nerviosos es algo universal, y es que existe un circuito (nervios) que conecta ambos órganos”, recuerda Casals-Pascual. Y como todas las conexiones, ésta también funciona en el doble sentido. “Hay observaciones, casi todas en modelos animales, que sugieren claramente que determinado tipo de microbiota puede afectar al estrés, la angustia-ansiedad, y por tanto, son susceptibles de ser modulados”, agrega.

La futura pastilla, de la que se podrían tener los primeros prototipos en 18/24 meses para empezar con los ensayos con pacientes, también podría incidir en la problemática de las bacterias resistentes a los antibióticos. “Se trata de un reto enorme”, apunta este investigador del Clínic. Si el tratamiento funcionara, se podría conseguir “la mejora del estado de salud de la población más envejecida, que actúa como vector de transmisión”. “Las personas mayores están colonizadas por bacterias muy resistentes a los antibióticos, y no tenemos nada que darles”, lamenta Casals-Pascual.En paralelo, si la pastilla resultara eficaz en la lucha contra estas bacterias resistentes sería una buena noticia para las arcas públicas, y es que supondría “una disminución sustancial de los presupuestos sanitarios”. Y todo ello gracias a la bajada de los recursos destinados a la obtención de antibióticos y a la disminución del tiempo de muchos ingresos hospitalarios.

Ahora, los investigadores centran sus esfuerzos en determinar qué grupo de bacterias quieren inserir dentro de la pastilla. “Hay miles y miles de especies diferentes, y unas son más beneficiosas que otras”, apunta el microbiólogo del Clínic. Lo que pretenden es encontrar “el cóctel final” que tenga “el beneficio máximo sobre el paciente”.Hay que tener en cuenta que el cuerpo del ser humano contiene un kilo y medio de bacterias. “Por cada célula humana tenemos nueve de bacterianas”, esgrime Casals-Pascual, quien concluye que somos “más bacterias que personas”.La idea es, una vez obtenida la pastilla y verificada su eficiencia a través de estudios clínicos, utilizarla en ambientes hospitalarios, “no buscando el beneficio económico”. Es lo mismo que están haciendo en Harvard, por ejemplo, donde existen bancos de microbiota. “Las venden a precio de coste”, apunta este investigador.Al final, el objetivo principal, tal y como sentencia este microbiólogo, es encontrar “una solución de bajo coste” a un problema, como es el de la resistencia a los antibióticos, “grave y urgente”. En este sentido, Casals-Pascual se muestra muy esperanzado. “Los próximos tres o cuatro años serán muy interesantes”, vaticina.Fuente: La Vanguardia
=> Recibir por Whatsapp las noticias destacadas